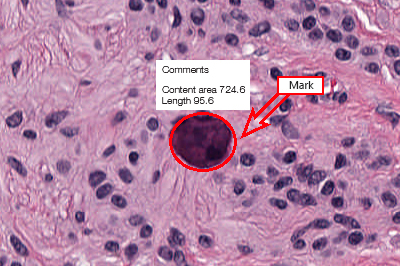

Vision Slide

Object analysis
Objects classification by specified criteria

Count and classification
Automatic or manual object identification on the digital slide.
Measurements of linear and optical parameteres for particles.
Marks and comments
Make your comments and put marks on a digital slide.
Administrative Module
Vision Remote

Remote workstation.
Consulting and Education Module
Vision Suite

Cloud/server for telemedicine and remote consultations with colleagues.
Download
West Medica | Histopathology